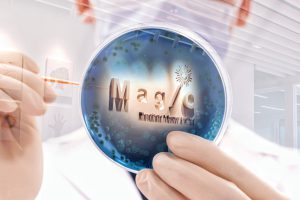

INNOVATIONS
Probiotic Composition for Immunity Enhancement
Innovations & Impacts
The trillions of bacteria including both beneficial and pathogenic ones residing in our guts contribute to the formation of gut microbiome which affects not only our gastrointestinal health but also immunity. In particular, probiotics is considered as a type of bacteria in the gut microbiota that is beneficial to the immune function. The formulation of probiotics to enhance immunity may therefore help with the prevention and treatment of diseases.
Through years of research in the field of gut microbiome and by the means of big data and machine learning, Professor Siew Chien NG of the Department of Medicine and Therapeutics, CUHK and her research team have identified the ideal bacterial species for pathogenic infections and developed a probiotic composition to effectively enhance immunity. The microbiome-based immunity formulas help prevent and treat pathogenic infections, including respiratory pathogen infections such as epidemic influenza and respiratory syncytial virus.
In 2019, Professor NG and her team founded GenieBiome Limited through the Technology Start-up Support Scheme for Universities (TSSSU) to develop the innovation into a marketable product. In response to the COVID-19 pandemic, the team has discovered not only the impact of the modulation of gut microbiota in reducing vaccine-related adverse reactions and improving the efficacy of COVID-19 vaccines, but also the severity of COVID-19 and its correlation with the patient’s gut microbiota composition, as well as the relationship between post-acute COVID-19 syndrome (long COVID) and gut microbiota composition. These ground-breaking discoveries help the team develop their product and hence launched a microbiome immunity formula as a dietary supplement that potentially hastens recovery and boosts antibody formation in patients with COVID-19 via restoration of the gut microbiome, bringing new remedies to combat against COVID-19.

From Research to Market
-

RESEARCH
-

ENTREPRENEURSHIP
-

IP & LICENSING
-

INNOHK
The research team led by Professor NG and Professor Francis CHAN of the Department of Medicine and Therapeutics, CUHK began their research on gut microbiome more than 5 years ago.
Supported by TSSSU, Professor NG and her team founded GenieBiome in 2019. The company was then admitted to the Incu-Bio Programme supported by the Hong Kong Science and Technology Parks Corporation (HKSTP). Their first product was launched in the market in late 2020. The company has raised over US$12.7 million external investment funding, striving to become one of the coming unicorns nurtured by CUHK.
G-NiiB (trademark of GenieBiome) has successfully obtained exclusive license from CUHK for the invention of using multiple novel bacterial markers in stool to not only detect colon cancer but also precancerous lesions (i.e., adenomas), and developed the G-NiiB CRCcore stool test. In addition, the company’s newly launched microbiome-based immunity formula is also based on the innovative discoveries exclusively licensed from CUHK. The team won a Gold Medal and a Silver Medal for their discoveries of “Specific Fecal Bacterial Markers of ASD” and “Level Up FMT Treatment” in the International Exhibition of Inventions Geneva 2022.
At the Centre for Gut Microbiota Research of the Faculty of Medicine, the research team led by Professor NG and Professor CHAN have made several impactful discoveries between the ideal group of gut microbiota and COVID-19. Their research is part of the Microbiota I-Centre (MagIC), one of our six InnoHK Centres under the Hong Kong government's InnoHK initiative located at HKSTP. The centre is committed to developing novel classes of microbiome diagnostics and therapeutics that will accelerate Hong Kong into a world-class microbiome biotechnology hub.
Media
-
CUHK researchers discover distinct gut microbial signatures for prediction, diagnosis and treatment of long COVID
2022 -
CU Medicine study shows distinct gut microbial profile associated with long COVID
2022 -
CUHK innovations excel at the International Exhibition of Inventions Geneva 2022
2022 -
中大醫學院全球首證有「長新冠型腸道微生態」 利用腸道微生態可準確預測、診斷及治療「長新冠」
2022 -
中大研究發現腸道微生態失衡與「長新冠」息息相關
2022 -
中大創新發明揚威2022年日內瓦國際發明展
2022